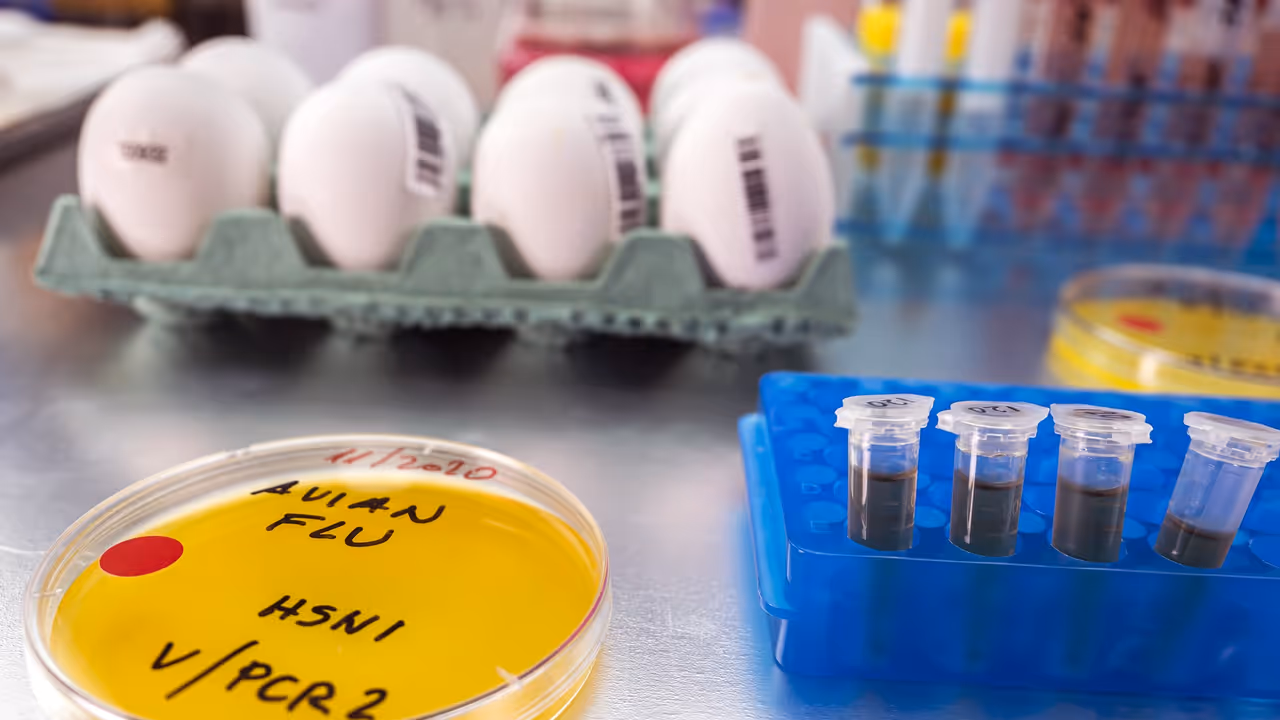

New research shows bird flu viruses can keep multiplying even at fever-level temperatures, unlike typical human flu. This temperature resistance may explain severe illness in rare human cases and raises concerns about pandemic potential.
A new study shows why certain bird flu strains may pose a serious threat to humans: they can continue spreading inside the body even during a fever — one of our strongest natural defenses. Scientists from the University of Cambridge discovered that bird flu viruses tolerate high temperatures that normally slow or stop human flu infections, raising new concerns about pandemic risks.

Bird Flu Can Replicate Even at Fever-Level Temperatures
When humans get sick, body temperature rises to slow viral replication. Most human flu viruses struggle to multiply when the body heats up to around 106°F (41°C). But bird flu viruses thrive in birds’ lower respiratory tracts and gut, where temperatures reach 104–108°F (40–42°C). These conditions match or exceed what the human body can achieve with a fever.
To test this, researchers infected mice with viruses engineered to behave like either human flu or bird flu. When mice were kept at fever-like temperatures, human-like viruses weakened — but bird flu-like viruses kept replicating and still caused severe illness.
Key Viral Genes Help Bird Flu Resist the Body’s Defenses
The team focused on PB1 genes — part of the virus’s copying machinery. Bird flu versions of these genes were far more temperature-resistant. Removing or altering them changed how severe infections became, suggesting this gene plays a major role in allowing bird flu to bypass the protective effect of fever.
Researchers say this may influence how doctors treat infected patients, as lowering fever could sometimes worsen disease instead of helping.
Why This Matters for Pandemic Preparedness
Bird flu rarely infects people, but when it does, fatality rates have historically been high. With H5N1 now widespread in birds, dairy cattle, and wildlife across the US, scientists stress that understanding temperature resistance may help identify strains more capable of causing severe human disease.
The findings also highlight the need for close surveillance, especially as cases continue appearing in humans from exposure to infected animals. The study is published in Science.